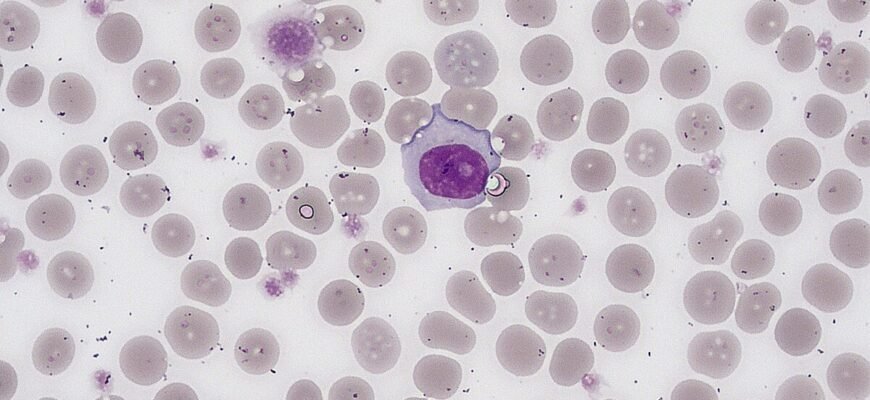
Підвищені тромбоцити у дитини: причини, симптоми та лікування Підвищені тромбоцити у дитини: причини, симптоми та лікування

Підвищені тромбоцити у дитини: що це означає?
Підвищені тромбоцити у дитини. Ось ця фраза сама собою насичена тривогою, викликає безліч запитань і хвилювань — не лише у батьків, а й у лікарів. Що ж це таке? Чи так це небезпечно, як звучить? Зараз ми про все це поговоримо.
Тромбоцити: таємничі клітини крові
Перш ніж зануритися в проблему, давайте зрозуміємо, що таке тромбоцити. Кров — це магічна субстанція. Вона переносить кисень, поживні речовини, видаляє продукти обміну… Серед усіх цих чарівних процесів, тромбоцити — це певні “захисники”, що виконують надзвичайно важливу роль.
- Тромбоцити — це малесенькі клітинки крові.
- Відповідають за згортання крові, інакше кажучи, вони рятують нас від зайвих крововтрат.
- Коли трапляється пошкодження судини, тромбоцити спрямовуються до цієї зони і створюють “заплатку”.
Ґрунт питань: чому ж тромбоцити підвищуються?
Отже, чому підвищені тромбоцити у дитини лякають нас? Коли їх стає забагато – це вже не є нормою. Часом, організм просто трішечки “вперта” система, і підвищена кількість тромбоцитів є тимчасовою реакцією. Та все ж, при таких змінах потрібна увага фахівця.
- Захворювання, запалення — навіть банальний грип може спричинити стрибок тромбоцитів.
- Дефіцит заліза. Кров сама натякає, наче: “Гей, час діяти!”
- Стрес, травма, хірургічне втручання — іноді ці фактори впливають.
Коли бити тривогу?
Красиво розповідати — це одне. Але, як зрозуміти, коли час діяти? Лікарі зазвичай орієнтуються на лабораторні показники. Та з дитячими організмами все завжди трохи складніше. Вони реагують так непередбачувано, що не встигаєш озирнутися. Але спробуємо пояснити якомога простіше.
| Вік | Норма тромбоцитів (×10⁹/л) |
|---|---|
| Новонароджені | 150-450 |
| До 1 року | 150-400 |
| Понад 1 рік | 150-350 |
Що робити? Дія або спокій?
Іноді достатньо просто трохи зловживати морквою і шпинатом, щоб відновити баланс. Інколи ж треба уважна діагностика. Що тут скажеш — медицина, як завжди, “лукавить”.
- Крок перший: не панікуймо. Перевіряймо двічі.
- Крок другий: звернутися до лікаря. Він обов’язково зорієнтує у вирії результатів аналізів. Можливо, знахонсе логічні пояснення.
- Крок третій: слідкуймо за дитиною. Просте правило — кращий запобіжник.
Стежимо за симптомами або хочемо заспокоїтись?
Чи є симптоми, які свідчать про підвищені тромбоцити у дитини? На жаль, не все так просто. Більшість дітей взагалі не дають жодних “сигналів” нездужання. Тому буває складно. Але іноді можна зауважити, що:
- Дитина часто без причини втомлюється.
- Спостерігаються синці там, де їх не мало б бути.
- Можуть бути болі голови, частішання пульсу.
Реакція організму: індивідуальність понад все
Ну от, що ж далі? Усі ми різні: відбитки пальців, смак в музиці і навіть реакція на хвороби варіюється. Залишається здаватись простим людським “витвором”, але з завзятістю. У випадку з дітьми — це справжній виклик, адже їх імунітет “вчиться” щодня. І тут уже важливо не загубити цей ключовий момент в вихованні імунної “свідомості”. Діти вчаться реагувати на атаки. Організм молодий, але вже тренується.
Підвищені тромбоцити у дитини зазвичай — тимчасове явище. Головне, відстежувати зміни і діяти, якщо це необхідно. Іноді найкраща порада — це просто не поспішати і трохи почекати. Дайте час імунній системі “відпрацювати” свої механізми. Лікарі часто сміються: “Зуби-то ростуть?” Так от, такі ж процеси відбуваються всередині нас щодня, непомітно і магічно.
Висновок? Будьте пильні, але спокійні
Якщо в лабораторії зазначено, що у дитини підвищений рівень тромбоцитів, не зволікайте з консультацією. Але і не впадайте в паніку. Життя, як і медицина, любить розкинутись сюрпризами. Пильність і спокій – ось два “солдати”, що стоять на сторожі здоров’я вашої дитини. Все решта, — це лише частинки великого пазла, який ми всі намагаємося скласти.
Лише знаний фахівець може допомогти з діагностикою та коригуванням лікування, якщо в цьому є потреба. Іноді просто треба почекати. Встояти. І давати тілу дитини час на власні способи самовідновлення…
І пам’ятаймо — імунітет дитини ще на своєму шляху становлення. Іноді йому потрібен простір для випробувань і помилок. І якщо вже йде мова про підвищені тромбоцити, завжди ввімкнуто радар на пошуки безпечного маршруту вперед.